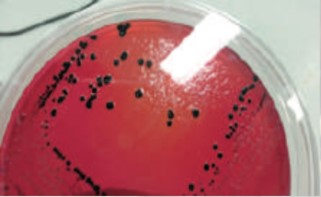

- Inicio
- Desarrollo e Investigación
- Desarrollo e Investigación
- EFICACIA DE UNA VACUNA TRIPLE INACTIVADA OLEOSA CONTRA Salmonella EN GALLINAS PONEDORAS INFECTADAS EXPERIMENTALMENTE CON Salmonella Enteritidis
EFICACIA DE UNA VACUNA TRIPLE INACTIVADA OLEOSA CONTRA Salmonella EN GALLINAS PONEDORAS INFECTADAS EXPERIMENTALMENTE CON Salmonella Enteritidis
ANTECEDENTES
El género Salmonella incluye más de 2.400 serotipos, la salmonelosis es una enfermedad infectocontagiosa que puede desarrollarse en humanos y en animales. En los últimos años en algunos países se han incrementado los casos de infecciones alimentarias por el consumo de alimentos con Salmonella sp. Es necesario un plan de control para prevenir la infección de alimentos de origen avícola con Salmonella sp., por tal razón como medida sanitaria se debe implantar un programa vacunal para suprimir la colonización y excreción de Salmonella sp.
OBJETIVO
Evaluar el efecto protectivo (excreción, invasión y colonización) de una vacuna triple (S. Typhimurium, S. Infantis y S. Enteritidis) oleosa inactivada en gallinas ponedoras de la línea Hy-line, contra la infección experimental de Salmonella.
MATERIALES Y MÉTODOS
El estudio se llevó a cabo en los laboratorios experimentales y laboratorio de I+D de Quimtia S.A. (Lurín-Perú).
Figura 1. Metodología

Cuadro 1. Diseño experimental: distribución de aves y programa de vacunación

Dosis infectiva, 1 x 107 UFC por vía intragluvial de SE.
RESULTADOS
Figura 2. Resumen de los resultados de hisopados cloacales

Figura 3. Resultados de muestras de órganos aislados

Cuadro 2. Acumulación de hisopados
cloacales positivos

a,b,c,d Las tasas de aislamiento en la misma columna sin superíndices comunes difieren
en la Prueba de Chi2 (P<0.05).
Figura 4. Crecimiento de bacterias de
Salmonella en agar XLD – Grupo 4
CONCLUSIÓN
Se redujo significativamente la invasión (hígados y bazos), colonización (ciegos) y excreción (hisopados cloacales) de Salmonella en las aves que recibieron la combinación vacunal de una o dos dosis de la vacuna inactivada con la 9R.
ARTÍCULOS RELACIONADOS
-
08.21.2025
REPORTE DE CASO: AISLAMIENTO E IDENTIFICACIÓN DE LA CEPA Q1 DEL VIRUS DE LA BRONQUITIS INFECCIOSA DE POLLOS COMERCIALES EN PERÚ
INTRODUCCIÓN El virus de la bronquitis infecciosa (IBV) causa una enfermedad del tracto respiratorio superior altamente contagiosa en los pollos, además de graves pérdidas económicas en la industria avícola de todo el mundo. El agente etiológico es un coronavirus aviar. Entre las proteínas estructurales del IBV, la subunidad S1 de la glicoproteína espiga es responsable […]Leer más -
08.21.2025
OBTENCIÓN DE INÓCULO Adenovirus aviar SEROTIPO 8b EN CÉLULAS LMH
OBJETIVO. El objetivo del estudio es producir un inóculo viral inactivado de Adenovirus aviar serotipo 8b (FAdV-8b) usando células LMH como plataforma de cultivo. MATERIALES Y MÉTODOS Línea Celular y virus. Célula de hepatoma de pollo (LMH) cultivada a 37°C y 5% de CO2 en medio DMEM, con 10% de Suero Bovino Fetal (SBF). Virus […]Leer más -
08.21.2025
CARACTERIZACIÓN MOLECULAR DE LA FIBRA DEL Adenovirus aviar GRUPO I
OBJETIVO El objetivo del estudio fue caracterizar la presencia del gen de la fibra de los serotipos de FAdV-4, 8b y 11 mediante la optimización de la Reacción en Cadena de la Polimerasa Múltiple (PCRm). MATERIALES Y MÉTODOS Extracción de ADN. Se extrajo el ADN de 20 aislamientos de Hepatitis por Cuerpos de Inclusión, recolectados […]Leer más -
08.21.2025
AISLAMIENTO Y GENOTIPIFICACIÓN DE Adenovirus aviar GRUPO I ASOCIADO A HEPATITIS CON CUERPOS DE INCLUSIÓN DE POLLOS COMERCIALES EN PERÚ
INTRODUCCIÓN Los adenovirus aviares (FAdV) tienen una distribución mundial y se han agrupado en 5 especies (A-E) con 12 serotipos: 1-8a a 8b-11. El hexón del adenovirus contiene determinantes antigénicos, la región del bucle hexón 1 (L1), representa la región más variable y, cuando se usa en la PCR junto con la secuenciación del ADN […]Leer más -
08.21.2025
PRUEBA DE POTENCIA DE UNA VACUNA INACTIVADA GELIFICADA CONTRA LA ENFERMEDAD DE NEWCASTLE: “INMUNOBROILER®”
OBJETIVO El objetivo del presente estudio fue evaluar, bajo condiciones experimentales, la protección e inocuidad de la vacuna inactivada gelificada Inmuno Broiler® de Quimtia S.A contra la Enfermedad de Newcastle (ENC) en pollos SPF. MATERIALES Y MÉTODOS Lugar y fecha de estudio El estudio se realizó en el Laboratorio de Patología Aviar de la Facultad […]Leer más -
08.21.2025
PROTECCIÓN CONFERIDA POR UNA BACTERINA OLEOSA TRIPLE FRENTE AL DESAFÍO DE Salmonella Typhimurium y S. Infantis
INTRODUCCIÓN Salmonella enterica subsp. enterica coloniza el tracto digestivo de humanos y de animales. Las salmonelas paratíficas causan enfermedades infectocontagiosas zoonóticas. En los últimos años se ha reportado un incremento de las infecciones alimentarias causadas por el consumo de alimentos con estas salmonelas. Para reducir la contaminación de los huevos para consumo y la de […]Leer más